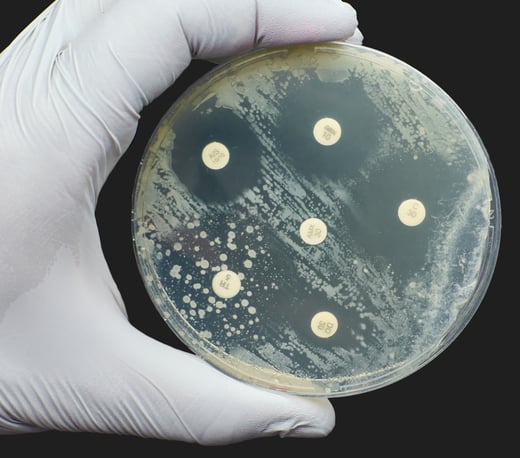

L'assunzione di una dose di doxiciclina entro 72 ore da un rapporto sessuale non protetto è da tempo una strategia utile per ridurre il rischio di alcune infezioni sessualmente trasmesse. Chiamata doxy PEP (post-exposure prophylaxis), viene raccomandata negli Stati Uniti, in Germania e in Australia e da poco è stata introdotta anche nel Regno Unito per le persone maggiormente a rischio. Ma se i dati clinici hanno dimostrato un calo significativo di clamidia e sifilide, un nuovo studio pubblicato sul New England Journal of Medicine ha segnala un rapido aumento della resistenza agli antibiotici nei ceppi di gonorrea.
INFEZIONI IN CRESCITA
Secondo i dati dell'Organizzazione Mondiale della Sanità, le infezioni sessualmente trasmesse rappresentano un problema sanitario globale in continua crescita. Negli ultimi anni i casi di sifilide e clamidia sono aumentati in modo costante, così come le infezioni da gonorrea. Proprio quest’ultima desta particolare preoccupazione: il batterio Neisseria gonorrhoeae è noto per la sua capacità di sviluppare resistenze e, nel tempo, ha reso inefficaci quasi tutte le classi di antibiotici impiegate. Oggi l’unico trattamento ancora affidabile resta la ceftriaxone. In questo scenario, l’introduzione del doxy PEP è stata accolta come un modo per ridurre la diffusione di sifilide e clamidia e abbattere il numero di nuove infezioni, ma fin dall’inizio ha sollevato timori legati al rischio di favorire nuove resistenze.
AUMENTANO LE RESISTENZE
Timori che si sono rivelati del tutto fondati. Nello studio da poco pubblicato, i ricercatori hanno analizzato oltre 14.000 sequenze genetiche di Neisseria gonorrhoeae raccolte tra il 2018 e il 2024 negli Stati Uniti. Dai dati è emerso un aumento netto del gene tetM, responsabile della resistenza alla tetraciclina: presente in meno del 10% dei campioni fino al 2020, nel 2024 è stato riscontrato in oltre il 30%, con picchi al 65% in alcune aree come il Pacifico Nordoccidentale. Segnali simili erano già stati riportati da studi locali e in altri batteri presenti nei soggetti che avevano fatto uso di doxy PEP, come Staphylococcus aureus e Streptococcus pyogenes.
PENSARE AD UN VACCINO
Doxy PEP si è dimostrata molto efficace nel ridurre i casi di sifilide e clamidia e, in misura minore, quelli di gonorrea. Ma l’aumento delle resistenze rischia di comprometterne i benefici, soprattutto a lungo termine. Per gli esperti la profilassi resta utile nelle popolazioni più esposte -in particolare per contenere la sifilide e le sue complicanze- ma va considerata come una soluzione temporanea. Secondo gli addetti ai lavori sarà quindi fondamentale intensificare la sorveglianza delle resistenze e sviluppare nuove strategie preventive -a partire da un vaccino contro la gonorrea- considerato l’obiettivo più promettente.